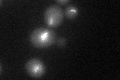
YLR304C
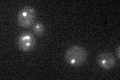
YLR304C

View description
Aconitase, required for the tricarboxylic acid (TCA) cycle and also independently required for mitochondrial genome maintenance; phosphorylated; component of the mitochondrial nucleoid; mutation leads to glutamate auxotrophy
Localization:
Intensity:
Fold change:
Significance:
-
C’ GFP library in SD

punctate22.59 -
N' NOP1pr-GFP in SD

mitochondria94.8462 -
N' TEF2pr-mCherry in SD

mitochondriaN/A -
N' NATIVEpr-GFP in SD

mitochondria25.2246 -
N' TEF2pr-VC and Cyto-VN in SD

#N/A0 -
C’ GFP library in SD+DTT
punctate20.760.91No -
C’ GFP library in SD+H2O2

punctate20.590.91No -
C’ GFP library in Starvation Media
punctate19.030.84No -
C’ GFP library on the background of Pup2-DaMP

punctate -
C’ GFP library on the background of CCT mutant

punctate25.47021.12716No
